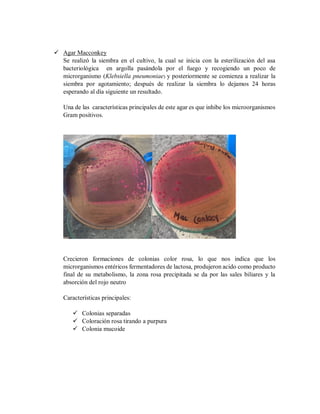
 Agar Macconkey
Se realizó la siembra en el cultivo, la cual se inicia con la esterilización del asa
bacteriológica en argolla pasándola por el fuego y recogiendo un poco de
microrganismo (Klebsiella pneumoniae) y posteriormente se comienza a realizar la
siembra por agotamiento; después de realizar la siembra lo dejamos 24 horas
esperando al día siguiente un resultado.
Una de las características principales de este agar es que inhibe los microorganismos
Gram positivos.
Crecieron formaciones de colonias color rosa, lo que nos indica que los
microrganismos entéricos fermentadores de lactosa, produjeron acido como producto
final de su metabolismo, la zona rosa precipitada se da por las sales biliares y la
absorción del rojo neutro
Características principales:
 Colonias separadas
 Coloración rosa tirando a purpura
 Colonia mucoide
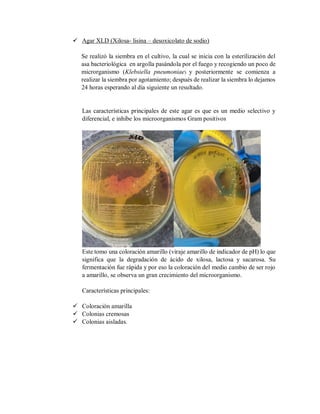
 Agar XLD (Xilosa- lisina – desoxicolato de sodio)
Se realizó la siembra en el cultivo, la cual se inicia con la esterilización del
asa bacteriológica en argolla pasándola por el fuego y recogiendo un poco de
microrganismo (Klebsiella pneumoniae) y posteriormente se comienza a
realizar la siembra por agotamiento; después de realizar la siembra lo dejamos
24 horas esperando al día siguiente un resultado.
Las características principales de este agar es que es un medio selectivo y
diferencial, e inhibe los microorganismos Gram positivos
Este tomo una coloración amarillo (viraje amarillo de indicador de pH) lo que
significa que la degradación de ácido de xilosa, lactosa y sacarosa. Su
fermentación fue rápida y por eso la coloración del medio cambio de ser rojo
a amarillo, se observa un gran crecimiento del microorganismo.
Características principales:
 Coloración amarilla
 Colonias cremosas
 Colonias aisladas.
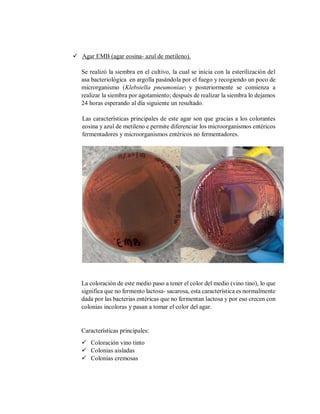
 Agar EMB (agar eosina- azul de metileno).
Se realizó la siembra en el cultivo, la cual se inicia con la esterilización del
asa bacteriológica en argolla pasándola por el fuego y recogiendo un poco de
microrganismo (Klebsiella pneumoniae) y posteriormente se comienza a
realizar la siembra por agotamiento; después de realizar la siembra lo dejamos
24 horas esperando al día siguiente un resultado.
Las características principales de este agar son que gracias a los colorantes
eosina y azul de metileno e permite diferenciar los microorganismos entéricos
fermentadores y microorganismos entéricos no fermentadores.
La coloración de este medio paso a tener el color del medio (vino tino), lo que
significa que no fermento lactosa- sacarosa, esta característica es normalmente
dada por las bacterias entéricas que no fermentan lactosa y por eso crecen con
colonias incoloras y pasan a tomar el color del agar.
Características principales:
 Coloración vino tinto
 Colonias aisladas
 Colonias cremosas
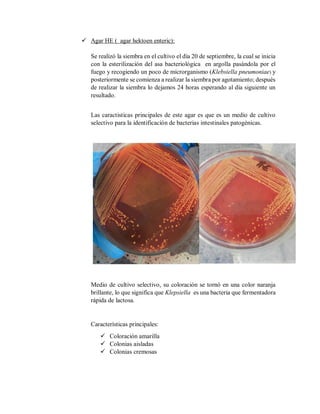
 Agar HE ( agar hektoen enteric):
Se realizó la siembra en el cultivo el día 20 de septiembre, la cual se inicia
con la esterilización del asa bacteriológica en argolla pasándola por el
fuego y recogiendo un poco de microrganismo (Klebsiella pneumoniae) y
posteriormente se comienza a realizar la siembra por agotamiento; después
de realizar la siembra lo dejamos 24 horas esperando al día siguiente un
resultado.
Las caractisticas principales de este agar es que es un medio de cultivo
selectivo para la identificación de bacterias intestinales patogénicas.
Medio de cultivo selectivo, su coloración se tornó en una color naranja
brillante, lo que significa que Klepsiella es una bacteria que fermentadora
rápida de lactosa.
Características principales:
 Coloración amarilla
 Colonias aisladas
 Colonias cremosas
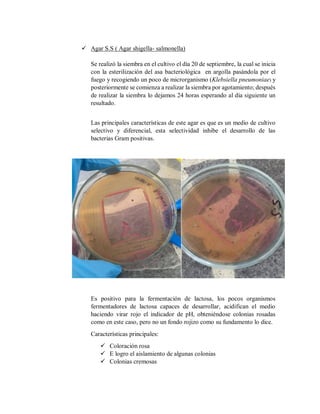
 Agar S.S ( Agar shigella- salmonella)
Se realizó la siembra en el cultivo el día 20 de septiembre, la cual se inicia
con la esterilización del asa bacteriológica en argolla pasándola por el
fuego y recogiendo un poco de microrganismo (Klebsiella pneumoniae) y
posteriormente se comienza a realizar la siembra por agotamiento; después
de realizar la siembra lo dejamos 24 horas esperando al día siguiente un
resultado.
Las principales características de este agar es que es un medio de cultivo
selectivo y diferencial, esta selectividad inhibe el desarrollo de las
bacterias Gram positivas.
Es positivo para la fermentación de lactosa, los pocos organismos
fermentadores de lactosa capaces de desarrollar, acidifican el medio
haciendo virar rojo el indicador de pH, obteniéndose colonias rosadas
como en este caso, pero no un fondo rojizo como su fundamento lo dice.
Características principales:
 Coloración rosa
 E logro el aislamiento de algunas colonias
 Colonias cremosas
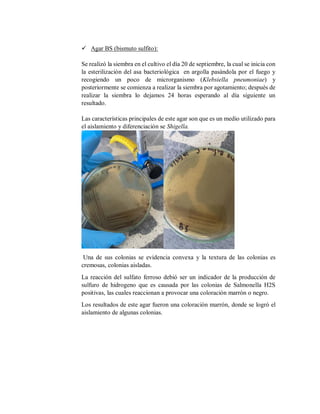
 Agar BS (bismuto sulfito):
Se realizó la siembra en el cultivo el día 20 de septiembre, la cual se inicia con
la esterilización del asa bacteriológica en argolla pasándola por el fuego y
recogiendo un poco de microrganismo (Klebsiella pneumoniae) y
posteriormente se comienza a realizar la siembra por agotamiento; después de
realizar la siembra lo dejamos 24 horas esperando al día siguiente un
resultado.
Las características principales de este agar son que es un medio utilizado para
el aislamiento y diferenciación se Shigella.
Una de sus colonias se evidencia convexa y la textura de las colonias es
cremosas, colonias aisladas.
La reacción del sulfato ferroso debió ser un indicador de la producción de
sulfuro de hidrogeno que es causada por las colonias de Salmonella H2S
positivas, las cuales reaccionan a provocar una coloración marrón o negro.
Los resultados de este agar fueron una coloración marrón, donde se logró el
aislamiento de algunas colonias.

El documento presenta el informe de laboratorio de una estudiante sobre el uso de medios selectivos y diferenciales para identificar bacterias. La estudiante realizó siembras en agar MacConkey, EMB, XLD, HE, SS, cetridime y BS inoculados con Klebsiella pneumoniae. Analizó el crecimiento bacteriano en cada medio y describió las características de las colonias como color, forma y reacción. El informe resume los objetivos y procedimientos realizados, y presenta consultas sobre el uso de diferentes medios en microbiología.